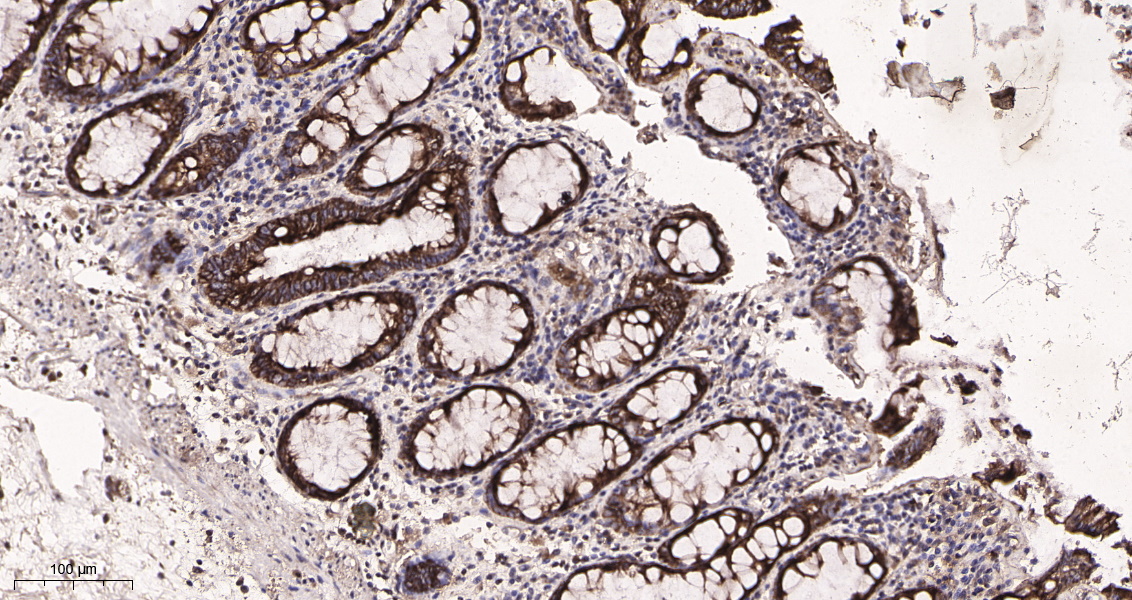

| Cat#: TR8024 | Source#: Rabbit | Type#: Monoclonal | |
 |
| Applications: WB,IHC-P,IF-P,IF-F,IF-ICC,IP,ELISA |
|
Reactivity: Human,Mouse,Rat |
| MW.(KDa): 55kDa |
Isotype: IgG, Kappa |
|
| The protein encoded by this gene, in combination with autophagy protein 12, functions as an E1-like activating enzyme in a ubiquitin-like conjugating system. The encoded protein is involved in several cellular processes, including autophagic vesicle formation, mitochondrial quality control after oxidative damage, negative regulation of the innate antiviral immune response, lymphocyte development and proliferation, MHC II antigen presentation, adipocyte differentiation, and apoptosis. Several transcript variants encoding different protein isoforms have been found for this gene. [provided by RefSeq, Sep 2015], |
|
|
| Western Blot |

Western blot analysis of lysates from U-87 MG cells, using ATG5 Rabbit mAb. The HRP-conjugated Goat anti-Rabbit IgG antibody was used to detect the antibody.
|
| Immunohistochemistry |
Immunohistochemical analysis of paraffin-embedded Human colon tissue. 1, primary Antibody was diluted at 1:200(4℃,overnight). 2, EDTA pH 9.0 was used for antibody retrieval(>98℃,20min). 3,Secondary antibody was diluted at 1:200(room tempeRature, 30min).
|
|
| |
|
|
| Storage |
Store at -20°C. Stable for one year from the date of shipment. |
| Concentration |
1mg/ml in PBS, pH 7.4, containing 0.02% sodium azide and 50% glycerol. |
| Dilutions |
IHC-P 1:200-1:1000, WB 1:2000-1:10000, IF-P/IF-F/IF-ICC 1:200-1:1000, ELISA 1:5000-1:20000, IP 1:50-1:200
(Optimal dilutions should be determined by the end user)
|
|
| |
|
| Autophagy protein 5 (APG5-like;Apoptosis-specific protein);APG5L;ASP |
| |
|
|
|
|
| Size: |
50μL ¥1300
100μL ¥2300 |
|
| New Product: |
|
|
|
| 直接下单: |
|
立即下单
|
|

